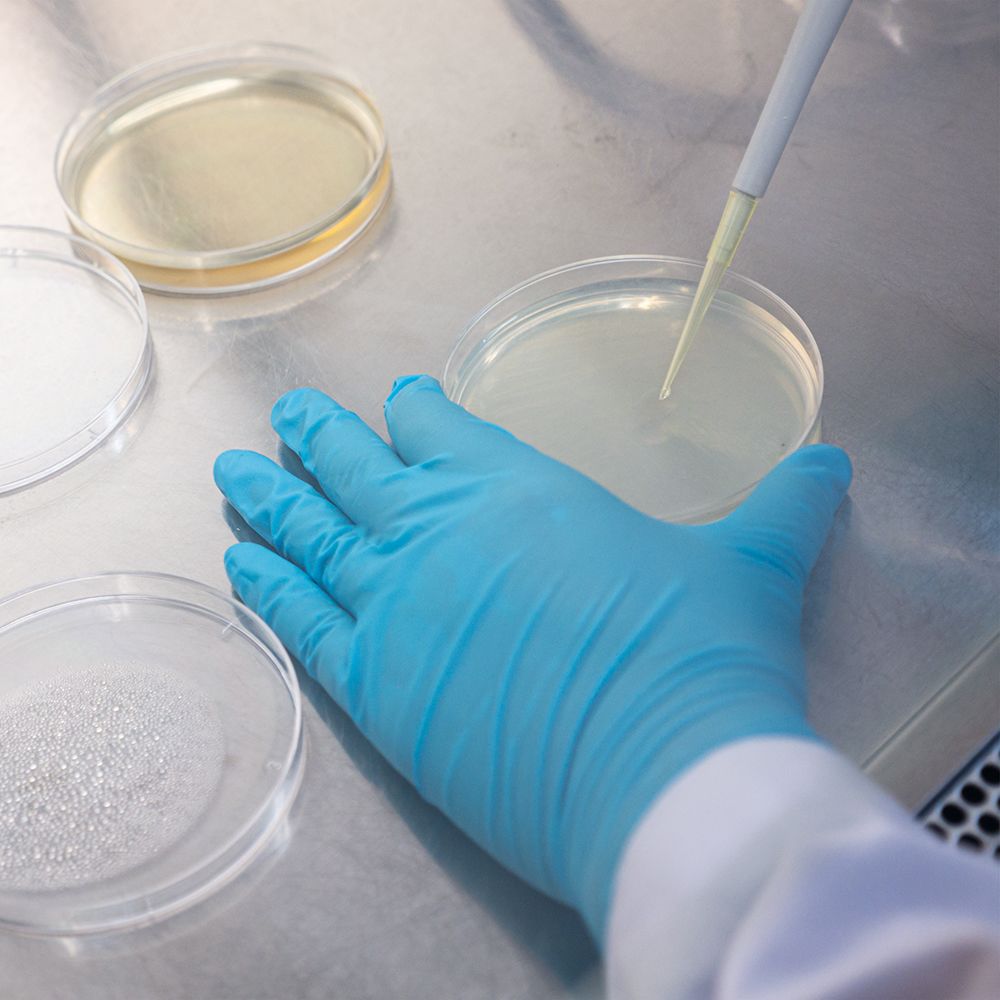

Respiratory

Respiratory

Respiratory
This section is dedicated to providing educational content for respiratory specialists, respiratory specialist nurses, and other healthcare professionals with an interest in respiratory medicine. It has CPD modules on asthma, chronic obstructive pulmonary disease (COPD), obstructive sleep apnoea (OSA), and lung cancer.
Dr Swapna Mandal
Consultant respiratory physician

Pulmonary rehabilitation for people with breathlessness


Module description
1 CPD hour
Physiotherapist Enya Daynes outlines the role of pulmonary rehabilitation (PR) to relieve breathlessness in people with chronic obstructive pulmonary disease (COPD) and other respiratory conditions.
Educational objectives
After completing this module, healthcare professionals should have a greater understanding of:
● The ‘breathing, thinking, functioning’ model of breathlessness
● The components of a PR programme
● The evidence for PR
Effect on life
Breathlessness, as a result of conditions such as chronic obstructive pulmonary disease (COPD), is a multifactorial and complex symptom that is distressing for the individual. It can lead to a vicious cycle of deconditioning in which people reduce their activities because of breathlessness and subsequently become more deconditioned and have reduced fitness. As a result of this further deconditioning, more and more physical tasks become difficult to perform.
The ‘breathing, thinking, functioning’ model of breathlessness provides a simplistic interpretation of the factors contributing to breathlessness and how this may manifest in different individuals.




Breathing
The pathophysiology that can contribute to breathlessness, such as increased work of breathing, use of accessory muscles, and changes in breathing mechanics (such as flattened diaphragm).
Thinking
The psychological contributors of breathlessness, such as misconceptions of diagnosis, thoughts of dying, previous experiences of breathlessness, and dyspnoea-related fear.
Functioning
The changes to day-to-day life that occur as a result of breathlessness, such as lack of independence, reduced muscle strength, and reduced exercise capacity.
Breathlessness can lead to a vicious cycle of deconditioning in which people reduce their activities because of breathlessness and subsequently become more conditioned
(Image credit: FG Trade/Getty Images)
Initial assessment
The American Thoracic Society (ATS) has outlined the key components of a PR programme.2 It states that the first step is an initial, centre-based, assessment by a healthcare professional with relevant training.
Exercise testing
The initial assessment should include exercise testing. The aim of exercise testing is to determine a patient’s maximum exercise tolerability — for example, their maximum voluntary oxygen uptake (VO2 max) — so that an individualised exercise programme can be designed at the appropriate intensity for the patient. Exercise testing can be in the form of a cardiopulmonary exercise test (CPET) or a field walking test, such as the incremental shuttle walking test or the six-minute walking test.
Other assessments
The initial assessment should also review the patient’s quality of life and the level of breathlessness. Breathlessness can be complicated to measure as there are many factors that contribute to it; however, the MRC Dyspnoea Scale can be used at rest and the Borg Rating of Perceived Exertion Scale can be used after exercise.

Exercise testing is an important part of the initial assessment and can include CPET
(Image credit: Andresr/Getty Images)
References
2. Holland A, Cox N, Houchen-Wolloff L et al. Defining modern pulmonary rehabilitation. Ann Am Thorac Soc 2021; 18(5): e12–29.
How it works
Both aerobic exercise training and resistance training, as part of an PR programme, can help to reduce the work of breathing in the following two ways:



Aerobic exercise training can prompt changes in the efficiency of the cardiovascular system.
Resistance training can lead to muscle adaptations, increasing muscle strength and efficiency, enabling the muscles to use oxygen more efficiently.



Aerobic exercise training can prompt changes in the efficiency of the cardiovascular system.
Resistance training can lead to muscle adaptations, increasing muscle strength and efficiency, enabling the muscles to use oxygen more efficiently.
The combination of aerobic exercise training and resistance training can improve physiology, reduce breathlessness, and subsequently increase a patient’s function. Through exercise training, supported by education, patients may become more comfortable with living with breathlessness. With a PR programme, patients can also learn additional techniques (such as breathing exercises and techniques to improve mood and anxiety), which can improve psychological (‘thinking’) aspects of breathlessness.
Additionally, PR can provide techniques on the management of breathlessness. These include: positioning, pursed-lip breathing, and ‘blow as you go’ breathing techniques that can improve the onset or recovery of breathlessness.
Through exercise training, supported by education, patients may become more comfortable with living with breathlessness.
(Image credit: Natnan Srisuwan/Getty Images)
Pulmonary rehabilitation for people with breathlessness
Physiotherapist Enya Daynes outlines the role of pulmonary rehabilitation (PR) to relieve breathlessness in people with chronic obstructive pulmonary disease (COPD) and other respiratory conditions.
Pulmonary rehabilitation for people with breathlessness
Physiotherapist Enya Daynes outlines the role of pulmonary rehabilitation (PR) to relieve breathlessness in people with chronic obstructive pulmonary disease (COPD) and other respiratory conditions.

Interstitial lung disease: clinical review


Module description
1.5 CPD hours
In this educational module, for respiratory physicians and other healthcare professionals with an interest in respiratory medicine, Drs Brintha Selvarajah and Richard Toshner discuss the aetiology, diagnosis, and management of interstitial lung disease (ILD). They look at idiopathic pulmonary fibrosis, connective tissue disease-associated ILD, and sarcoidosis.
Educational objectives
After taking this activity healthcare professionals should be better able to:
● Describe the different categories of ILD
● Understand which investigations are used in the diagnosis of ILD
● Discuss the management options for ILD and how these differ depending on the type of ILD
Introduction
Interstitial lung disease (ILD) is an umbrella term that describes a heterogeneous group of diseases, characterised by varying degrees of inflammation and/or fibrosis of the lung parenchyma.
Although ILD conveys a substantial burden of morbidity and mortality worldwide, there is significant heterogeneity in the outcomes across different subtypes. Accurate stratification of different ILDs into treatment-response based classifications, therefore, has a direct impact upon management strategies and patient outcomes.
However, the complicated myriad of acronyms attributed to the spectrum of imaging, histological and clinical manifestations of ILD can be daunting (see next page for a list of key abbreviations). This review aims to provide a practical guide to the diagnosis and management of ILD.

ILD is an umbrella term describing a heterogenous group of diseases
(Image credit: Sebastian Kaulitzki/Science Photo Library/Getty Images)
Categorisation
ILD can be classified into six main aetiological categories:
Idiopathic interstitial pneumonias (IIPs)
CTD and vasculitis-related ILD
Inhaled materials
Drugs
Sarcoidosis
Rare diseases
Investigations



Physical examination
A physical examination can identify the following:
● End-inspiratory fine crackles
● Scattered end-inspiratory squeaks, which may suggest a bronchiolitis (including RB-ILD or HP)
● Signs of pulmonary hypertension and cor pulmonale (loud P2, right ventricular heave and peripheral oedema)
● Finger clubbing, which can be a sign of IPF and asbestosis
● Extrapulmonary features of systemic disease, which in particular can be seen in CTD- and vasculitis-associated pathologies
Investigations
Routine investigations include:
● Serological
● Radiological
● Histological confirmation, which is used when the diagnosis is unclear. Lung biopsy is preferentially performed surgically, but confers a high risk of morbidity and mortality. Therefore, when possible, it should be avoided.3



Physical examination
A physical examination can identify the following:
● End-inspiratory fine crackles
● Scattered end-inspiratory squeaks, which may suggest a bronchiolitis (including RB-ILD or HP)
● Signs of pulmonary hypertension and cor pulmonale (loud P2, right ventricular heave and peripheral oedema)
● Finger clubbing, which can be a sign of IPF and asbestosis
● Extrapulmonary features of systemic disease, which in particular can be seen in CTD- and vasculitis-associated pathologies
Investigations
Routine investigations include:
● Serological
● Radiological
● Histological confirmation, which is used when the diagnosis is unclear. Lung biopsy is preferentially performed surgically, but confers a high risk of morbidity and mortality. Therefore, when possible, it should be avoided.3
References
3. Fisher JH, Shapera S, To T et al. Procedure volume and mortality after surgical lung biopsy in interstitial lung disease. Eur Respir J 2019; 53(2): 1801164.
Interstitial lung disease: clinical review
Drs Brintha Selvarajah and Richard Toshner discuss interstitial lung disease (ILD) in this educational module. They look at idiopathic pulmonary fibrosis, connective tissue disease-associated ILD, and sarcoidosis.
Interstitial lung disease: clinical review
Drs Brintha Selvarajah and Richard Toshner discuss interstitial lung disease (ILD) in this educational module. They look at idiopathic pulmonary fibrosis, connective tissue disease-associated ILD, and sarcoidosis.

Diagnosing and managing acute hypercapnic respiratory failure


Module description
1 CPD hour
In this module for healthcare professionals with an interest in respiratory medicine, Dr Anita Saigal reviews the diagnosis and management of acute hypercapnic respiratory failure (AHRF). She also looks at the common conditions, including chronic obstructive pulmonary disease (COPD), that can lead to AHRF.
Educational objectives
After taking this activity healthcare professionals should be better able to:
● Describe the pathophysiology of AHRF
● Understand which conditions are commonly associated with AHRF
● Discuss management strategies for AHRF
Definitions
The respiratory system consists of the lung (the gas exchanging organ) and the pump (that is the chest wall, the respiratory muscles, and nerves linking respiratory centres within the central nervous centre to those muscles).1 If the respiratory muscles have an excessive increased load upon them, feedback mechanisms will modify the central drive to alter the ventilatory pattern and reduce the load.
Normal levels of carbon dioxide (CO2) tension in the arterial blood (PaCO2) arise as a balance between the rate of CO2 production and the portion eliminated by the lung from alveolar ventilation. If the ventilatory pump becomes exhausted, or ineffective (either from a rise in the dead space within the lung or from a reduction of minute ventilation), then this can result in alveolar hypoventilation and hypercapnia.

Acute hypercapnic respiratory failure (AHRF) is defined biochemically as a pH of <7.35 (acidosis) and an arterial PaCO2 >6kPa. When AHRF persists after initial medical therapy, these threshold values are used to determine the need for acute management with non-invasive ventilation.2 More severe degrees of acidosis, such as a pH of <7.25, may be used to determine the need for invasive ventilation; although, other clinical observations (respiratory rate, blood pressure, heart rate or oxygen saturations) are vital for this decision-making.2
If the ventilatory pump becomes exhausted, or ineffective, this results in alveolar hypoventilation and hypercapnia
(Image credit: zf L/Getty Images)
The tables below outline the common factors that are associated with the causes of AHRF.




CNS inactivation
Mechanical defects
Muscular fatigue
Generally, the symptoms and signs of AHRF depend on the underlying condition.

Patients with COPD often present with dyspnoea, cough, sputum production and wheeze.

The main symptoms of OHS are usually because of lack of sleep and include excessive daytime sleepiness, headaches, tiredness and associated complications such as mood disturbance or car traffic accidents. Often, OHS patients can be misdiagnosed and up to one third may be diagnosed when they are hospitalised.14

The principal symptoms and signs of neuromuscular disease include muscular weakness, muscle wasting, rigidity, loss of muscular control, which leads to swallowing difficulties, fatigue, and breathing difficulties.
Patients with respiratory failure ultimately present with a wide variety of symptoms as a consequence of the resultant hypoxaemia and hypercapnia, and these processes can cause a change in the person’s appearance and behaviour. Common symptoms and signs include dyspnoea, anxiety, confusion and cardiac abnormalities.
References
14. Sequeira TCA, BaHammam AS, Esquinas AM. Noninvasive ventilation in the critically ill patient with obesity hypoventilation syndrome: a review. J Intensive Care Med 2017; 32(7): 421–8.
Diagnosing and managing acute hypercapnic respiratory failure
In this module for healthcare professionals with an interest in respiratory medicine, Dr Anita Saigal reviews the diagnosis and management of acute hypercapnic respiratory failure (AHRF).
Diagnosing and managing acute hypercapnic respiratory failure
In this module for healthcare professionals with an interest in respiratory medicine, Dr Anita Saigal reviews the diagnosis and management of acute hypercapnic respiratory failure (AHRF).
Identifying and managing COPD-OSA overlap syndrome
1 CPD hour
In this module, for healthcare professionals with an interest in respiratory medicine, Dr Amar Shah reviews chronic obstructive pulmonary disease (COPD) and obstructive sleep apnoea (OSA) overlap syndrome. He looks at prevalence, burden of disease, and management.
Educational objectives
After taking this activity healthcare professionals should be better able to:
● Describe the characteristics and diagnostic criteria for isolated COPD, isolated OSA, and for COPD-OSA overlap syndrome
● Discuss the burden disease of COPD-OSA overlap syndrome
● Review management options for COPD-OSA overlap syndrome
Diagnosis and management of aspergillosis
1.5 CPD hours
In this CPD module for respiratory specialists, Drs Laura Macfarlane, Rebecca Thomas, and Chris Kosmidis (from the National Aspergillosis Centre) outline the diagnosis, types, and management of the respiratory disease aspergillosis, which results from exposure to the common environmental mould Aspergillus.
Educational objectives
After taking this activity healthcare professionals should be better able to:
● The pathophysiology of aspergillosis
● The different types of aspergillosis
● The risks and benefits of antifungal treatment
Cough augmentation in neuromuscular disease
1 CPD hour
Neuromuscular respiratory physiotherapist Charlotte Massey outlines the role of cough augmentation, an airway clearance technique, in supporting people with neuromuscular disease.
Educational objectives
After taking this activity healthcare professionals should be better able to:
● How neuromuscular disease can affect coughing ability
● How coughing ability is measured
● Indications for cough augmentation
● Types of cough augmentation
COPD and CVD: two sides of the same coin?
1 CPD hour
In this on-demand webinar, for healthcare professionals with an interest in respiratory medicine, Dr Richard Russell looks at the relationship between chronic obstructive pulmonary disease (COPD) and cardiovascular disease (CVD).
Educational objectives
After taking this activity healthcare professionals should be better able to:
● The common risk factors for COPD and CVD
● The mortality and morbidity associated with co-existing COPD and CVD
● Treatment options for COPD
Identifying and managing COPD-OSA overlap syndrome
1 CPD hour
In this module, for healthcare professionals with an interest in respiratory medicine, Dr Amar Shah reviews chronic obstructive pulmonary disease (COPD) and obstructive sleep apnoea (OSA) overlap syndrome. He looks at prevalence, burden of disease, and management.
Educational objectives
After taking this activity healthcare professionals should be better able to:
● Describe the characteristics and diagnostic criteria for isolated COPD, isolated OSA, and for COPD-OSA overlap syndrome
● Discuss the burden disease of COPD-OSA overlap syndrome
● Review management options for COPD-OSA overlap syndrome
Diagnosis and management of aspergillosis
1.5 CPD hours
In this CPD module for respiratory specialists, Drs Laura Macfarlane, Rebecca Thomas, and Chris Kosmidis (from the National Aspergillosis Centre) outline the diagnosis, types, and management of the respiratory disease aspergillosis, which results from exposure to the common environmental mould Aspergillus.
Educational objectives
After taking this activity healthcare professionals should be better able to:
● The pathophysiology of aspergillosis
● The different types of aspergillosis
● The risks and benefits of antifungal treatment
Cough augmentation in neuromuscular disease
1 CPD hour
Neuromuscular respiratory physiotherapist Charlotte Massey outlines the role of cough augmentation, an airway clearance technique, in supporting people with neuromuscular disease.
Educational objectives
After taking this activity healthcare professionals should be better able to:
● How neuromuscular disease can affect coughing ability
● How coughing ability is measured
● Indications for cough augmentation
● Types of cough augmentation
COPD and CVD: two sides of the same coin?
1 CPD hour
In this on-demand webinar, for healthcare professionals with an interest in respiratory medicine, Dr Richard Russell looks at the relationship between chronic obstructive pulmonary disease (COPD) and cardiovascular disease (CVD).
Educational objectives
After taking this activity healthcare professionals should be better able to:
● The common risk factors for COPD and CVD
● The mortality and morbidity associated with co-existing COPD and CVD
● Treatment options for COPD